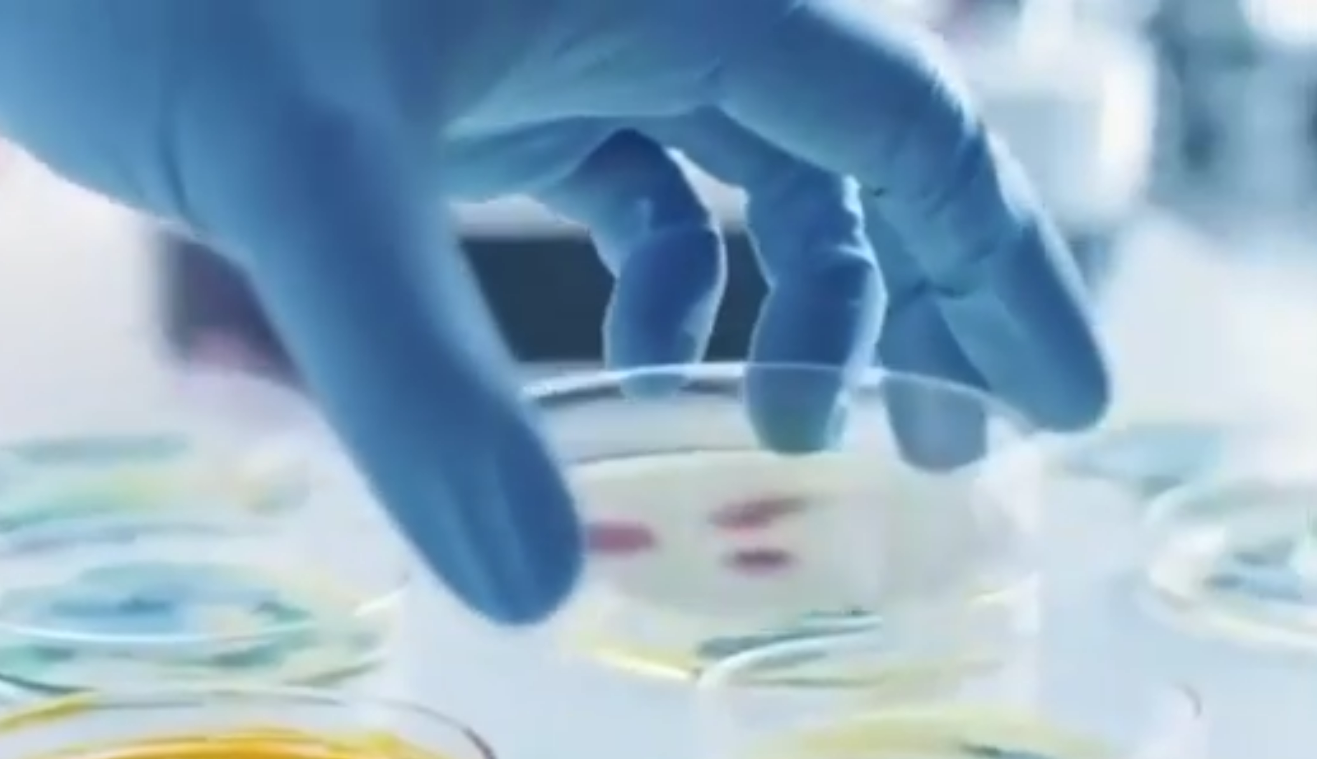

缅甸政府正在拆除KK园区148栋建筑
据报道,缅甸政府9日表示,他们正在拆除KK园区内的148栋建筑。在这些建筑中,除了用于从事非法诈骗活动的建筑外,还有生活设施建筑,包括六层楼酒店、健身房、两层楼SPA会所、两层楼KTV、四层楼医院和食堂等。此外,KK园区内还设有公园、体育场、五人制足球场、篮球场等。

缅甸政府称,目前,KK园区所有建筑均在拆除中,已拆除101栋,剩余47栋正在拆除。在通过边境路线非法进入KK园区从事犯罪活动的外国人中,逾90%是经泰国越境进入缅甸。
今年10月,缅甸国防军突袭了臭名昭著的KK园区,抓获了2000多名诈骗犯,还有1500人逃往泰国。当地居民称,随着拆除工作的继续,不时听到爆炸声。缅甸国防军还查获30套星链接收器及配件。而星链母公司SpaceX随后表示,该公司已在缅甸电诈园区周边识别出超过2500台“星链”设备,并且禁用了这批设备。
新研究从药物生产中发现超强抗生素
“超级细菌”指那些对多种抗生素具有耐药性的细菌。研究人员在一种常用药物的生产流程中意外发现一种很有前景的强效抗生素,能够杀死耐甲氧西林金黄色葡萄球菌等“超级细菌”。相关研究论文近期已发表在《美国化学学会杂志》上。
澳大利亚莫纳什大学在新闻公报中介绍,该校研究人员在与英国华威大学的联合项目中发现了一种被称为前次甲霉素C内酯的抗生素,这是在制备常用抗生素次甲霉素A的过程中产生的一种中间化学物质。
此次研究发现,次甲霉素A合成过程中的一种中间体——前次甲霉素C内酯,对多种革兰氏阳性菌的抗菌活性比原始抗生素次甲霉素A高100倍以上,其中就包括最令医学界头疼的耐甲氧西林金黄色葡萄球菌和耐万古霉素肠球菌。研究人员说,这一发现为寻找新型抗生素提供了一个新的模式。
尹锡悦看守所内接收逾6.5亿韩元代管金
韩国法务部9日发布的资料显示,前总统尹锡悦在看守所被羁押期间共接收超过6.5亿韩元(约合318万元人民币)代管金,引发外界对该制度遭滥用、沦为政治资金筹措渠道的质疑。

看守所代管金用于在押人员购买洗漱用品等生活必需品,任何人均可汇款。根据相关规定,代管金存入笔数和总额没有限制,在看守所内使用金额上限为400万韩元(约合2万元人民币),超出部分可在被羁押期间或获释后提取。
韩国法务部向祖国革新党国会议员朴恩贞提交的资料显示,尹锡悦7月10日再次被捕至10月26日,累计接收超过6.5亿韩元代管金。其妻子金建希接收约2250万韩元(约合11万元人民币)代管金。
美国9日航班取消量超2000架次
当地时间9日,航班追踪网站FlightAware的数据显示 ,截至美国东部时间当日16时,美国单日航班取消数量首次超过2000架次,创下自政府“停摆”削减航班措施开始以来的新高。同时延误航班也超过7000架次。

据悉,美国政府持续“停摆”和联邦航空管理局强制削减4%的航班,已经造成了航空旅行方面的诸多不便,而空中交通管制人员短缺的问题更是雪上加霜。天气也加剧了混乱局面,一股冷空气于9日和10日席卷美国东部地区。预计未来一周,航空公司将被迫逐步减少航班,导致更多航班取消和延误,除非美国国会能够达成一项拨款妥协方案,重新开放政府。
因剪辑拼接特朗普视频,BBC高管辞职
当地时间11月9日下午,英国广播公司(BBC)总裁蒂姆·戴维与新闻部门首席执行官黛博拉·特内斯引咎辞职。导火索是外界批评BBC《全景》栏目通过剪辑拼接美国总统特朗普的演讲视频误导观众。

英国《每日电讯报》近日曝光一份BBC内部备忘录,披露BBC涉嫌拼接特朗普2021年1月6日的演讲视频,使其看起来似乎在煽动当天的国会山暴乱。
这份19页的备忘录由BBC标准委员会前顾问迈克尔·普雷斯科特撰写,重点指证了一段在去年美国大选前一周于BBC《全景》栏目中播出的视频。该视频基于特朗普2021年1月6日的演讲内容剪辑拼接而成。备忘录中指出,BBC的剪辑“制造了一种假象,使观众误以为特朗普发表了实际上并未说过的话,构成严重误导”。
拜登狠批特朗普:让国家蒙羞
美国前总统拜登(下图)近日批评他的继任者特朗普,称这位现任总统不仅拆掉了白宫东翼,也毁掉了美国“民主”制度。

这位现年82岁的前总统批评特朗普拆除白宫部分区域并希望改造成宴会厅。特朗普此前说他的宴会厅计划“不会影响现有建筑”。
报道称,拜登说:“这是他总统任期的完美象征。特朗普不仅毁掉了白宫和宪法,而且还毁掉了法制和我们的民主制度。”拜登还称,这位现任总统用自己的行为让国家蒙羞,还把有钱人的利益置于普通美国人之上。
乌总统签署新一轮对俄制裁决定,涉及多名俄官员
当地时间11月9日,乌克兰总统泽连斯基签署新的制裁决定,针对多名俄罗斯政府官员及机构实施制裁措施。据悉,制裁名单中包括俄罗斯总统特别代表基里尔·德米特里耶夫等人。

乌克兰呼吁国际社会扩大对俄罗斯的压力,制裁所有资助战争及传播虚假信息的个人和机构。乌方称本轮乌克兰制裁名单包括“参与掠夺被占乌克兰地区的俄罗斯政府成员”、俄罗斯军事情报部门人员等。乌方还计划对俄罗斯境内从事战争宣传和侵略辩护的出版机构采取进一步措施。
佩斯科夫:俄方正等待美方澄清恢复核试验言论

俄罗斯总统新闻秘书佩斯科夫(上图)9日表示,美国总统特朗普近期宣布计划恢复核试验的言论,给人一种美国打算在不久的将来开始核试验的印象。对此俄罗斯需要得到澄清。佩斯科夫说,俄罗斯总统普京并未下令直接开始准备核试验,如果有其他国家违反核试验禁令,俄方将被迫采取对等措施以维护战略平衡。
特朗普10月30日表示,由于其他国家正在进行核试验,他已命令五角大楼立即对等启动核武器试验。
伊朗将启动货币改革:删除面值末四个零

伊朗宪法监护委员会日前已批准伊朗货币面值调整计划,将通过货币改革,删除伊朗货币面值末四个零。该调整将在未来五年内逐步完成。
伊朗中央银行官员表示,此次面值调整更多是结构性与象征性改革,并不会改变货币的实际价值。
最新民调:四分之一德国人希望默克尔回归
据德国《世界报》网站11月8日报道,在安格拉·默克尔(基民盟)卸任总理近4年后,一项调查显示,四分之一的德国人希望她回归。丰克媒体集团委托西韦舆论调查公司进行的这项调查显示,默克尔在绿党和左翼党的支持者、年轻选民以及城市居民中尤其受欢迎。

报道称,针对“是否怀念默克尔担任联邦总理的时期”这一问题,总计25%的受访者表示“怀念”或“比较怀念”,而68%的受访者选择“不怀念”或“不太怀念”。在表示将在下次联邦议院选举中投票给左翼党的受访者中,61%的人称怀念默克尔(上图),绿党支持者中这一比例为52%。联盟党(基民盟/基社盟)支持者中这一比例仅为22%,社民党支持者中这一比例为34%。
调查显示,默克尔在18至29岁群体中最受欢迎,该年龄段三分之一的受访者表示怀念这位前总理。而在65岁以上人群中,这一比例仅为19%。调查还揭示了城乡地区支持率的差异:地区城市化程度越高,人们对这位前总理的怀念就越强烈。
(羊城晚报•羊城派综合央视新闻、新华社、参考消息网、红星新闻、澎湃新闻等)